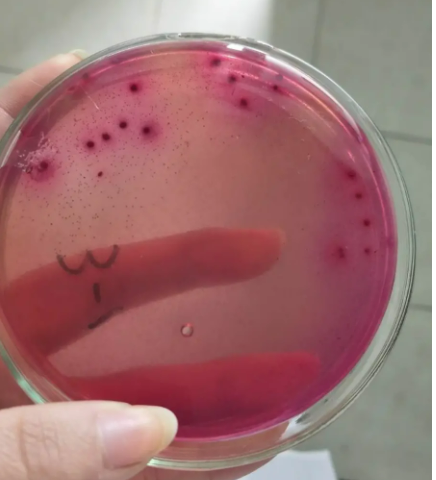

一、确定检测方法
目前针对菌落总数测定的现行有效国家标准为:GB 4789.2-2016《食品安全国家标准 食品微生物学检验 菌落总数测定》(2022.12.30日废止,2022版即将实施)
针对大肠菌群测定的现行有效国家标准有:GB/T 4789.3-2003《食品卫生微生物学检验 大肠菌群测定》、GB 4789.3-2016《食品安全国家标准 食品微生物学检验 大肠菌群计数》大肠菌群两种检测方法;结果单位分别为:2003版—MPN/100g(mL);2016版—MPN计数:MPN/g(mL);平板计数法 CFU/g(mL)。
可以根据食品标准或企业标准中的卫生指标确定大肠菌群的检测方法。

如某企业生产鸡粉调味料,行业标准中规定:大肠菌群(MPN/100g)≤150,则选用2003版的检测方法;若单位为MPN/g(mL),则选用2016版MPN多管发酵法,若单位为CFU/g(mL),则选用2016版的平板计数法。
二、菌落总数的概念及卫生意义
食品检样经过处理,在一定条件下(如培养基、培养温度和培养时间等)培养后,所得每g(mL)检样中形成的微生物菌落总数。
按国家标准方法规定,即在需氧情况下,37℃培养48h,能在平板计数琼脂培养基上生长的细菌菌落总数,所以厌氧或微需氧菌、有特殊营养要求的以及非嗜中温的细菌,由于现有条件不能满足其生理需求,故难以繁殖生长。
因此,菌落总数并不表示实际中的所有细菌总数,也不能区分其中细菌的种类,所以有时被称为杂菌数或需氧菌数。
三、菌落总数的测定
菌落总数的常规检验方法菌落总数的常规检验方法(GB4789.2-2016):
基本操作一般包括:样品的稀释——倾注平皿——培养48小时——计数报告。

四、菌落总数的计数
根据菌落形成单位(CFU)进行计数,简单来说就是数平板上长了多少个小圆点(可添加0.1%TTC在平板计数琼脂中,菌落呈红色,更方便计数),菌落生长状况大体可以分为四种情况:
1、无蔓延菌落
这种情况的菌落计数可以直接数小圆点,低于30CFU的平板记录具体菌落数,大于 300CFU的可记录为多不可计。

2、 片状菌落
这种情况下不宜采用,若两个平行平板都出现片状菌落需重做实验。

3、 半片状半无蔓延菌落
若片状菌落不到平板的一半,而其余一半中菌落分布又很均匀,即可计算半个平板菌落后乘以2,代表一个平板菌落数。

4、链状菌落
当平板上出现菌落间无明显界线的链状生长时,则将每条单链作为一个菌落计数。

五、大肠菌群的概念及卫生意义
大肠菌群并非细菌学分类命名,而是卫生细菌领域的用语,它不代表某一个或某一属细菌,而指的是具有某些特性的一组与粪便污染有关的细菌,这些细菌在生化及血清学方面并非完全一致,其定义为:需氧及兼性厌氧、在37℃能分解乳糖产酸产气的革兰氏阴性无芽胞杆菌。
一般认为该菌群细菌可包括大肠埃希氏菌、柠檬酸杆菌、产气克雷白氏菌和阴沟肠杆菌等。
对于4789.3-2016MPN计数法中:
推测试验:样品稀释后,选择三个稀释度,每个稀释度接种三管LST肉汤。36±1℃培养48±2h,观察是否产气。
证实试验:将产气管培养物接种煌绿乳糖胆盐(BGLB)肉汤管中,36±1℃培养48±2h,观察是否产气。以BGLB产气为阳性。查MPN表,报告每ml(g)样品中大肠菌群的MPN值。
为方便大家使用和观看,为大家总结MPN法检验大肠菌群的流程如下:


对于4789.3-2016平板计数法中平板菌落数的选择:
典型菌落为紫红色,菌落周围有红色的胆盐沉淀环,菌落直径为0.5mm或更大。
可疑大肠菌群菌落,部分符合典型菌落特征的菌落,比如以下平皿中:
1、紫红色圆形菌落,菌落周围有透明圈;
2、紫红色梭型菌落,菌落较小菌落周围无沉淀圈,都算是可疑大肠菌群菌落。
按比例挑取10个不同类型的典型和可疑菌落,少于10个菌落的挑取全部典型和可疑菌落。假如在1:10的平板上可疑大肠菌群有10个,典型大肠菌群有6个,证实实验应该按照可疑跟典型5:3的比例进行挑取,移种于BGLB肉汤管内。
六、订购信息

收下名片,带你玩转逗点多元宇宙